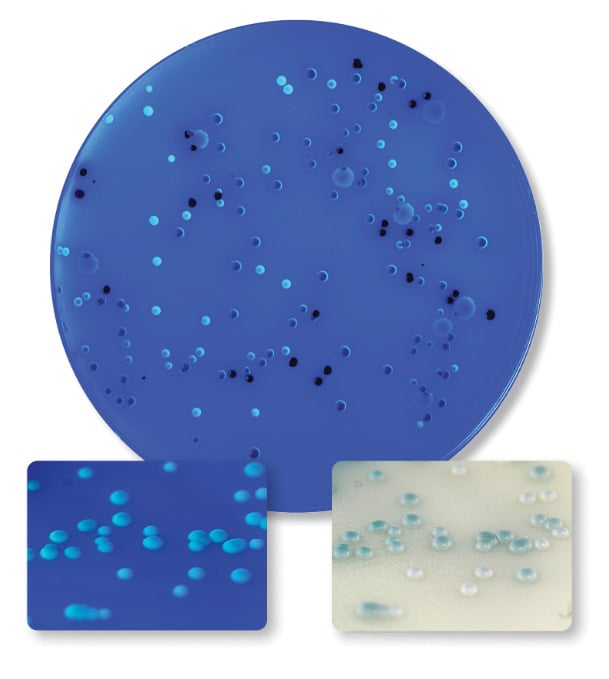

December 2021—Hardy Diagnostics has released its HardyChrom Candida plus auris, a chromogenic media recommended for the selective isolation and differential identification of Candida species. This medium allows for the identification of C. albicans, C. tropicalis, and C. krusei, and the presumptive identification of C. glabrata. Colonies of C. auris will appear white with a characteristic teal to teal-green bull’s-eye center. C. auris is also differentiated from other Candida species by a unique fluorogenic reaction under UV light.
Hardy Diagnostics, 805-346-2766

